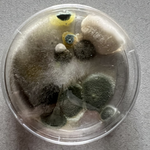
Our Projects

Serving Livonia, MI and surrounding areas
Approved
In business since 2005
Emergency services offered
Warranties offered
"I live in a condo, with common walls. The structure was built in the 1940's so there are plenty of places along those common walls where sounds and smells can seep through. A few months ago, because of a negligent neighbor and her 10-cats, a horrible odor was entering my space. Strong ammonia smell among others as a result of the uncleaned cat boxes. I looked a company to do air quality testing, testing the air for ammonia to document the situation. While the test sample was being evaluated by the lab, the fee I paid, included use of a professional air purifier, which was a life saver as it did clear away the smell. Access to this device and service was a lifesaver, for me, as the issue with the neighbor was being resolved. Moral of the story is that I needed a service done, was very happy with the customer service provided."





+43